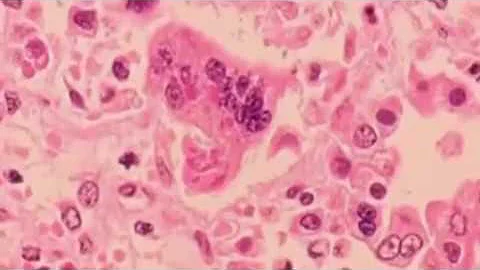
Measles outbreak nearing largest in two decades

External Source
Largest Measles Outbreak In Decades
Synopsis
Southwest Utah is part of the nation's largest active measles outbreak, shared with northern Arizona. Join Mindy Bundy (Nursing ...
Download Options
Choose a download method below. All links open in new tabs.
| Service | Features | Action |
|---|---|---|
| SaveFrom |
MP4 & MP3 • HD Quality • Browser Extension Available
|
Download |
Security Notice: These are third-party services. We recommend using antivirus software and being cautious of pop-up ads.